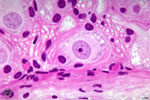
Τα δορυφορικά κύτταρα στην αποκατάσταση των μυϊκών βλαβών

Μεταμόσχευση βλαστικών κυττάρων στη θεραπεία της μυϊκής δυστροφίας
Λονδίνο: Ένας νέος τρόπος χειραγώγησης των ανθρώπινων εμβρυονικών βλαστικών κυττάρων μπορεί να προσφέρει ελπίδες θεραπείας των μυϊκών δυστροφιών, σύμφωνα με στοιχεία που δημοσιεύονται στο επιστημονικό έντυπο Nature Medicine.

Αριθμός Πιστοποίησης Μ.Η.Τ.232442
Αριθμός Πιστοποίησης Μ.Η.Τ.232442